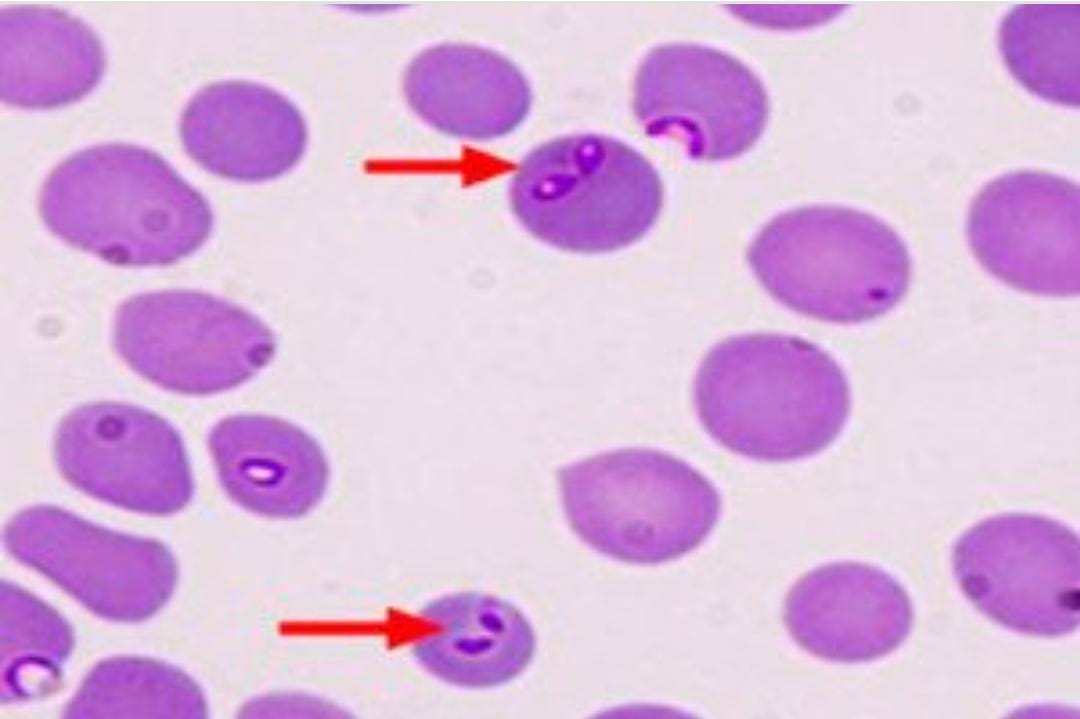
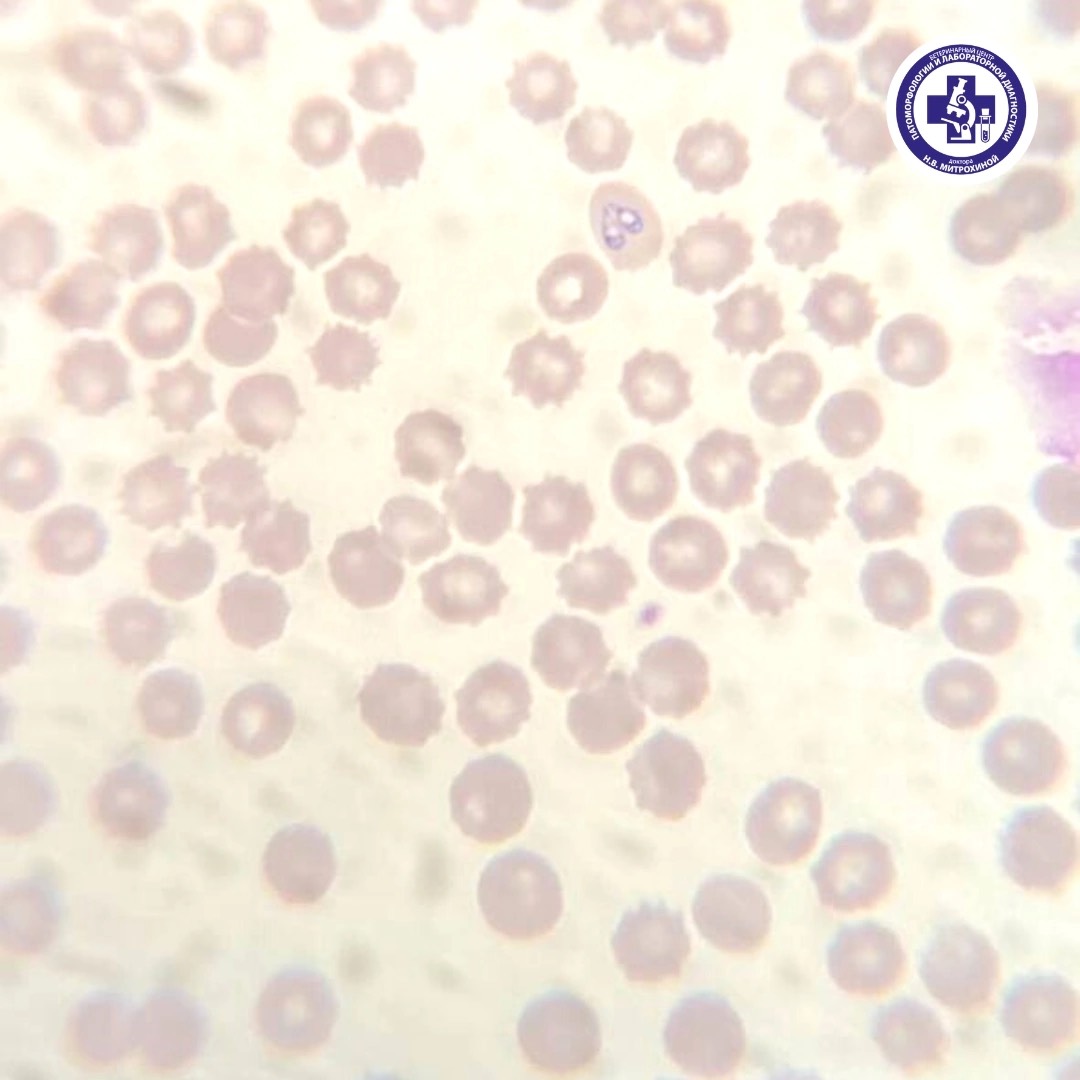
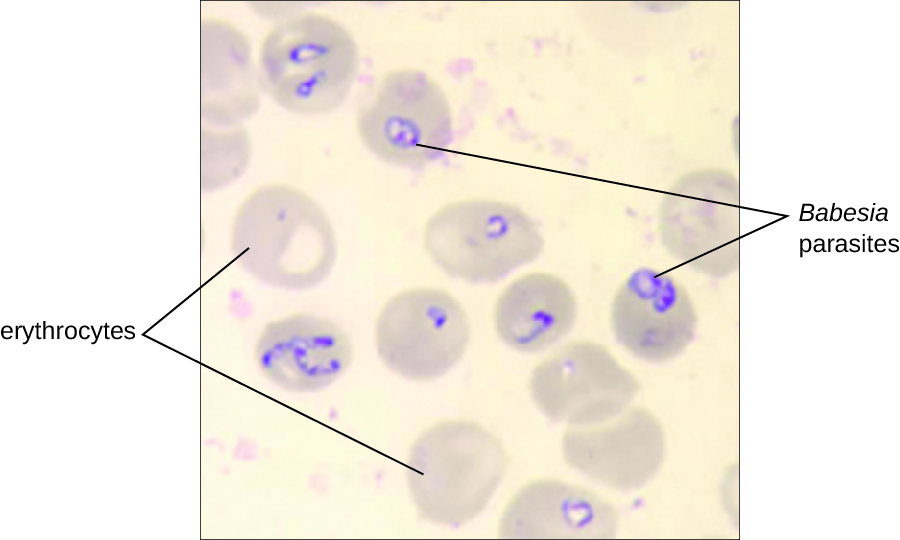

Мазок на пироплазмоз
Какой сегодня праздник в корее южной
Причина развода прилучного
Игра друзья не скачивая
Фитнес хаус открылся
Газхимкомплект
Почему все не так как всегда
Я найду тебе замену
18 августа екатеринбург
Мяч 2021 года
Индукционные варочные панели ginzzu
Сайлент блок
Повтор фото
374 4
Мазок на пироплазмоз 115 фото